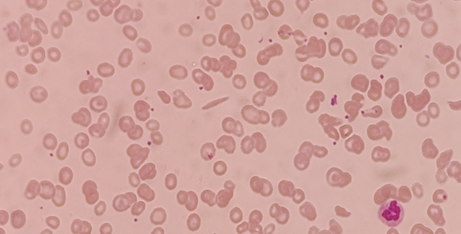

6360abefb0d6371309cc9857
Abstract
Mycoplasma pneumoniae
(MP) is a frequent cause of community-acquired respiratory infections in
children and adults, especially in school-aged children. It is also responsible
for a wide spectrum of non- pulmonary manifestations including hematological, gastrointestinal,
renal, cardiac and central nervous system involvement. Pneumonia in young
adults, serum cold hemagglutinins in a titre of 1:64, a positive IgM MP
antibody, polymerase chain reaction or effective treatment with macrolides can
be helpful for confirming the diagnosis.
Keywords: Mycoplasma pneumonia; Nervous system; Sickle cell anemia;
Nebulization
Introduction
We present a case of a
11 year 7-month-old male child who was brought to the hospital with history of
moderate to high grade fever (1 spike per day) in the evening which subsided
with administration of oral antipyretics. In the inter-febrile period of 14
days there was associated non spasmodic, non-productive cough not severe enough
to disturb his sleep. He was admitted to an outside hospital on the second day
of illness, where he received IV antibiotics, a pint of packed cells, round the
clock nebulization and symptomatic treatment.
However, symptoms
persisted and he was shifted to a tertiary care hospital on day 9 of illness
and was started on IV antibiotics (Inj Piperacillin tazobactam, Inj Vancomycin)
and oral Oseltamivir for 5 days as well as Oral Doxycycline for 3 days along with
round the clock nebulization.
His fever and cough
reduced in intensity, however as symptoms persisted, he was referred to our
hospital.
The patient was
admitted and started on Inj. Ceftriaxone and was continued on oral Doxycyxline.
Based on the clinical
presentation, a comprehensive radiological evaluation was initiated.
Chest radiograph
revealed an ill-defined opacity in the left mid zone (Figure 1).
Figure 1: Chest radiograph
revealing an ill-defined opacity in the left middle zone (arrow)
Ultrasonography
revealed splenomegaly with coarse echotexture of the spleen which showed an
overall increase in echotexture. Multiple focal hypoechoic lesions were seen in
the spleen. Possibility of an infective or neoplastic lesion was suggested (Figure
2).
Figure 2: A- USG of spleen
showing enlarged spleen showing coarse echotexture and multiple well defined
hypoechoic lesions in the spleen
B- Colour Doppler of
spleen showing normal splenic artery and lesions not showing vascularity
Based on the USG images, MRI
was performed and revealed a spleen which was T1 and T2 hypointense with a
coarse appearance with presence of multiple well defined minimally hyperintense
lesions as compared to the rest of the splenic parenchyma on the T1 and T2 weighted images (Figure 3).
Figure 3: A- T2 coronal image showing coarse echotexture of spleen
with multiple hyperintense lesions
B-
Fat saturated axial T1 weighted image
showing no suppression of signal
CT
done in an outside hospital was suggestive of ground glass opacities in the
left upper and right middle lobes and lingula. Consolidation was noted in the
right lower lobe and lingula. Mediastinal lymphadenopathy was also noted (Figure 4).
Figure 4: Revealing consolidation surrounded by ground glass opacities
in the right middle and left lingula
Microbiology
revealed raised titers of IgM Mycoplasma (> 27).
Peripheral
blood smear revealed sickling of the red blood cells.
Parents’
HPLC : positive : heterozygous (HbS = 38.5%) (Figure 5).
Figure 5: Peripheral blood smear image revealing sickling of the red
blood cells
Discussion
Mycoplasma
pneumoniae is a common cause of atypical pneumonia in children, typically
presenting with mild to moderate respiratory symptoms. However, its course and
complications can be more severe in patients with underlying chronic diseases,
such as sickle cell disease (SCD). This case highlights the unique diagnostic
and clinical challenges when Mycoplasma infection occurs in a child with SCD.
Children with SCD
are predisposed to a range of pulmonary complications, including acute chest
syndrome (ACS), pneumonia, and pulmonary infarction1. Distinguishing
Mycoplasma pneumonia from other causes of lung infiltrates in these patients
can be challenging because clinical and radiological features often overlap.
ACS, for example, is a leading cause of morbidity and mortality in SCD and is
commonly precipitated by infections, fat embolism, or pulmonary infarction.
Mycoplasma species have been identified as one of the infectious triggers for
ACS, underlining the importance of accurate diagnosis and prompt treatment.
Radiologically,
Mycoplasma pneumonia often presents with round pneumonia, patchy, peribronchial
or interstitial infiltrates, which may be unilateral or bilateral. However, in
children with SCD, differentiating findings of pulmonary infarction from bacterial
/ round pneumonia can be difficult.
Chest radiographs
and high-resolution CT may reveal consolidation, ground-glass opacities, or
atelectasis - findings that overlap significantly with other pulmonary
complications of SCD. In our patient, imaging demonstrated splenic lesions
which, along the diagnosis.
Young children with
sickle cell anaemia are at risk for acute splenic sequestration crises2. In paediatric
sickle cell anaemia patients, the spleen undergoes a continuum of changes.
Initially, there can be splenomegaly due to acute splenic sequestration.
Repeated episodes of sickling can cause atrophy, fibrosis and ultimately
asplenia. The coarse echotexture observed on ultrasound in this patient was
suggestive of chronic irreversible changes within the splenic parenchyma
reflecting areas of fibrosis, hemosiderin deposition and previous
microinfarctions.
While mycoplasma is
not typically recognized as a primary cause of direct splenic abscesses or
lesions, the compromised immune function inherent in SCA patients makes them
susceptible to secondary infections2.
This case
underscores the importance of a comprehensive approach to paediatric patients
with sickle cell anaemia where imaging findings must be interpreted in light of
both the underlying haematological disorder and any concurrent acute
infections.
This case emphasizes
the need for a high index of clinical suspicion, careful radiological
evaluation, and early microbiological testing in SCD patients presenting with
respiratory symptoms. It also emphasizes the radiologist’s role in recognizing
imaging patterns that raise suspicion for atypical infections in the setting of
an underlying haematological disorder. It is important to communicate these
findings to the clinical team to guide prompt management.
References